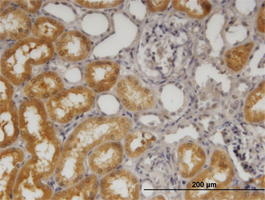

Filters
Clonality
Type
Reactivity
Gene Name
Isotype
Host
Application
Clone
2745 results for " Recombinant Antibodies" - showing 950-1000
GAPDH, Monoclonal Antibody (Cat# AAA26252)
PKNOX2, Monoclonal Antibody (Cat# AAA25502)
FTL, Monoclonal Antibody (Cat# AAA26014)
GCH1, Monoclonal Antibody (Cat# AAA24223)
CDH11, Monoclonal Antibody (Cat# AAA26012)
FTL, Monoclonal Antibody (Cat# AAA26011)
CDC2, Monoclonal Antibody (Cat# AAA24753)
SNRPA, Monoclonal Antibody (Cat# AAA25257)
NR3C1, Monoclonal Antibody (Cat# AAA25772)
HMGB1, Monoclonal Antibody (Cat# AAA26028)
SORD, Monoclonal Antibody (Cat# AAA25259)
CD58, Monoclonal Antibody (Cat# AAA24751)
SRPK1, Monoclonal Antibody (Cat# AAA25263)
FTL, Monoclonal Antibody (Cat# AAA26543)
PEPD, Monoclonal Antibody (Cat# AAA25786)
FKBP4, Monoclonal Antibody (Cat# AAA24508)
DCPS, Monoclonal Antibody (Cat# AAA14781)
Purified by Protein A affinity chromatography.
PCNA, Monoclonal Antibody (Cat# AAA25487)
2019-03-07, Monoclonal Antibody (Cat# AAA25744)
FKBP4, Monoclonal Antibody (Cat# AAA24212)
MEOX2, Monoclonal Antibody (Cat# AAA25750)
GROS1, Monoclonal Antibody (Cat# AAA24228)
NDUFV2, Monoclonal Antibody (Cat# AAA25764)
FTL, Monoclonal Antibody (Cat# AAA26277)
NKX3-1, Monoclonal Antibody (Cat# AAA25768)
FTL, Monoclonal Antibody (Cat# AAA26280)
VRK2, Monoclonal Antibody (Cat# AAA24998)
CDH11, Monoclonal Antibody (Cat# AAA26278)
FGL2, Monoclonal Antibody (Cat# AAA24505)
OPA1, Monoclonal Antibody (Cat# AAA26552)
RPS7, Monoclonal Antibody (Cat# AAA25527)
FGL2, Monoclonal Antibody (Cat# AAA14772)
Purified by Protein A affinity chromatography.
GATA2, Monoclonal Antibody (Cat# AAA24517)
NFKB1, Monoclonal Antibody (Cat# AAA26565)
NEK11, Monoclonal Antibody (Cat# AAA14794)
Purified by Protein A affinity chromatography.